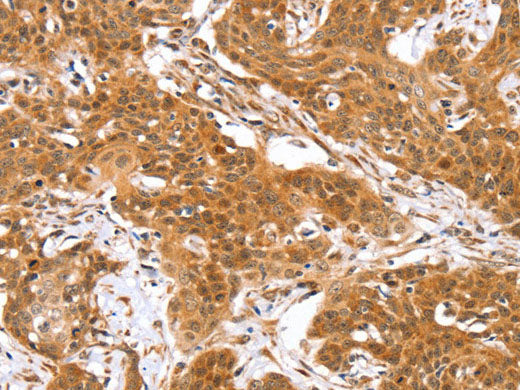
RGS22 Polyclonal Antibody

RGS22 Polyclonal Antibody
Couldn't load pickup availability

Still have questions? Ask our experts!
RGS22 Polyclonal Antibody
| SKU # | E-AB-11537 |
| Reactivity | Human |
| Host | Rabbit |
| Applications | WB, IHC |
Product Details
| Isotype | IgG |
| Host | Rabbit |
| Reactivity | Human |
| Applications | WB, IHC |
| Clonality | Polyclonal |
| Immunogen | Recombinant protein of human RGS22 |
| Abbre | RGS22 |
| Synonyms | FLJ40080, FLJ75004, MGC102908, PRTD-NY2, RGS22, Regulator of G-protein signaling 22 |
| Swissprot | |
| Calculated MW | 147 kDa |
| Cellular Localization | Nucleus, Plasma Membrane, Other locations: cytoplasm. |
| Concentration | 0.3 mg/mL |
| Buffer | Phosphate buffered solution, pH 7.4, containing 0.05% stabilizer and 50% glycerol. |
| Purification Method | Affinity purification |
| Research Areas | Signal Transduction |
| Conjugation | Unconjugated |
| Storage | Store at -20°C Valid for 12 months. Avoid freeze / thaw cycles. |
| Shipping | The product is shipped with ice pack,upon receipt,store it immediately at the temperature recommended. |
Related Reagents
| Applications | Recommended Dilution |
| WB | 1:500-1:2000 |
| IHC | 1:25-1:100 |
Background
RGS22 (regulator of G-protein signaling 22), also known as FLJ75004, PRTD-NY2, FLJ40080, MGC102908 or DKFZp434I092, is a novel 1264 amino acid regulator of G-protein signaling specific to to testis. RGS22 inhibits signal transduction and contains two isoforms as a result of alternative splicing. RGS22 is found in spermatogenic cells and Leydig cells, and may be involved in the translocation of GNA13 from the cytoplasm to the nucleus during spermiogenesis. RGS22 contains two RGS domains: RGS1 and RGS2, and the gene encoding RGS22 maps to human chromosome 8q22.2.